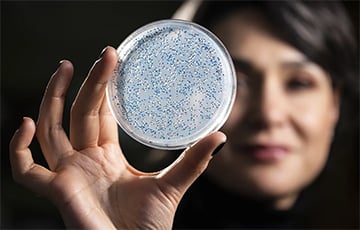
Ученые впервые приблизились к разгадке происхождения жизни

Ученые впервые приблизились к разгадке происхождения жизни
- 26.01.2026, 15:12
- 4,392
В центре исследования оказался фермент нитрогеназа.
Исследователи из Университета Висконсин–Мэдисон с помощью методов синтетической биологии воссоздали древнейший фермент, существовавший более 3,2 миллиарда лет назад, и изучили его работу внутри живых микроорганизмов. Результаты помогут лучше понять, как зарождалась жизнь на Земле, а также дадут новые ориентиры для поиска возможных признаков жизни за ее пределами. Работа опубликована в журнале Nature Communications (NatCom).
В центре исследования оказался фермент нитрогеназа — ключевой биологический «инструмент», позволяющий превращать атмосферный азот в форму, доступную для живых организмов. Этот процесс лежит в основе существования практически всей биосферы. По словам руководителя работы, профессора бактериологии Бетюль Качар, без нитрогеназы жизнь в привычном нам виде просто не могла бы возникнуть.
В отличие от традиционных подходов, основанных на анализе редких геологических находок, ученые применили обратную эволюционную реконструкцию. Они восстановили предполагаемую структуру древней версии нитрогеназы на основе современных ферментов, «встроили» ее в геном бактерий и проследили, как она функционирует в лабораторных условиях.
Это позволило заглянуть в эпоху, когда на Земле еще не было кислорода в привычных концентрациях, а жизнь существовала преимущественно в виде анаэробных микроорганизмов. В те времена атмосфера была богата углекислым газом и метаном, а доступ к азоту был критически важным условием выживания.
Особое внимание исследователи уделили так называемым изотопным сигнатурам — химическим «следам», которые ферменты оставляют в горных породах. До сих пор ученые исходили из предположения, что древние ферменты формировали такие же изотопные соотношения, как и современные. Однако прямых доказательств этому не существовало.
Эксперимент показал, что, несмотря на существенные различия в ДНК древней и современной нитрогеназы, механизм, отвечающий за формирование изотопных сигнатур азота, за миллиарды лет практически не изменился. Это подтверждает корректность интерпретации древних геологических данных и делает такие сигнатуры надежным индикатором биологической активности в прошлом.
Полученные результаты имеют значение не только для изучения истории Земли, но и для астробиологии. Теперь ученые получили более надежный «эталон» биосигнатур, по которым в будущем можно будет искать следы жизни на других планетах.







